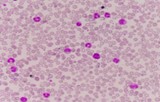
CAR-T cells

Cell and gene therapy are rapidly evolving thanks to breakthroughs in gene editing. Next-generation CRISPR technologies have significantly improved precision and minimized off-target effects, enhancing the safety and efficacy of gene therapies. These advances enable the treatment of a wider range of genetic diseases by allowing highly specific correction of disease-causing mutations.
Emerging In Vivo Cell Reprogramming Approaches
A promising frontier in cell and gene therapy (CGT) is in vivo cell reprogramming, which involves directly modifying cells inside the patient’s body. This approach has the potential to treat complex conditions such as heart disease and neurodegenerative disorders without the need for labor-intensive ex vivo cell manipulation, simplifying treatment and potentially lowering costs.
Expansion of RNA-Based Therapeutics
Building on the success of mRNA vaccines, RNA-based therapies are gaining traction beyond infectious diseases. Engineered RNA molecules are being developed to modulate immune responses and target cancer and autoimmune diseases, showcasing the versatility and therapeutic potential of RNA platforms in cell and gene therapy.
Innovations in Delivery Systems
Effective delivery of genetic material remains a critical challenge. Recent innovations in both viral and non-viral vectors are improving tissue targeting, reducing immune reactions, and enhancing the overall safety profile of gene therapies. These advances are essential for expanding the applicability of CGT to a broader patient population.
Manufacturing and Scalability Challenges
Despite scientific progress, manufacturing personalized cell and gene therapies at scale remains complex and costly. Variability in donor cells, stringent quality control requirements, and supply chain logistics necessitate advanced automation and process optimization. Emerging decentralized and point-of-care manufacturing models aim to improve accessibility and reduce production costs.
Evolving Regulatory Landscape
Regulatory agencies worldwide are adapting frameworks to keep pace with rapid CGT innovations. Streamlined approval processes and guidelines for distributed manufacturing are being developed to ensure patient safety while facilitating faster access to breakthrough therapies. This evolving landscape supports the growing number of clinical trials and approved CGT products.